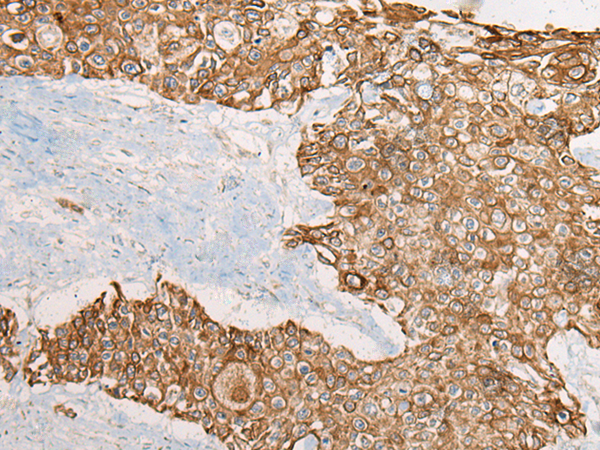

-
分类: 科研抗体货号: P02445别名: CLI; AAG4; APOJ; CLU1; CLU2; KUB1; SGP2; APO-J; SGP-2; SP-40; TRPM2; TRPM-2; NA1/NA2应用: IHC反应种属: Human, Rat
-
分类: 科研抗体货号: P02366别名: UTY1; KDM6AL应用: IHC反应种属: Human
-
分类: 科研抗体货号: P02430别名:应用: WB,IHC反应种属: Human
-
分类: 科研抗体货号: P02443别名: CT3; CT95; CTAG3; bA69L16.7应用: WB,IHC反应种属: Human
-
分类: 科研抗体货号: P02429别名: C1orf93; FAM213B应用: WB,IHC反应种属: Human, Mouse, Rat
-
分类: 科研抗体货号: P02466别名: MBC1应用: WB,IHC反应种属: Human, Mouse
-
分类: 科研抗体货号: P02441别名: RCD4应用: IHC反应种属: Human
-
分类: 科研抗体货号: P02420别名: TIM21; HSPC154; C18orf55应用: WB,IHC反应种属: Human
-
分类: 科研抗体货号: P02464别名: RaRF应用: WB,IHC反应种属: Human
-
分类: 科研抗体货号: P02437别名: C4BP应用: IHC反应种属: Human

鄂公网安备42018502007531号
鄂公网安备42018502007531号

